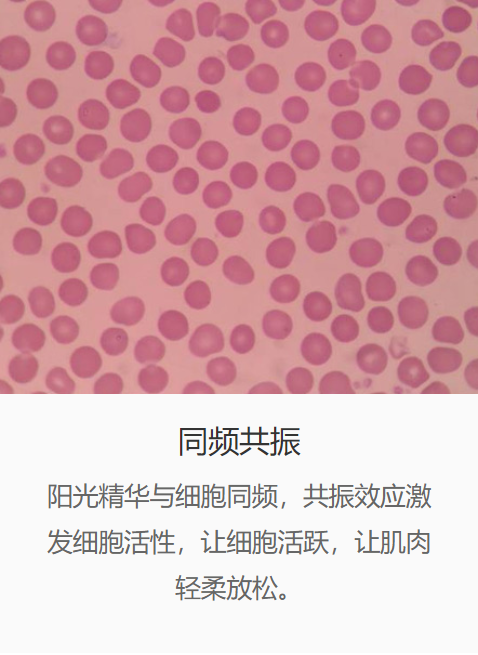

发布时间:2021-07-31
一只羊、两只羊、三只羊……哎!又是一个不眠夜!

看你那国宝级的黑眼圈、赛过兔子的红眼睛、乱如鸟窝的头发,这应该是失眠症吧!
据数据统计显示,每100个人里面就有30~50人翻来覆去睡不着;还有10~20人已经连续一个月没有睡过好觉了。

医学上说,失眠症就是睡眠启动和维持障碍,导致睡眠质量不能满足个人需求,并影响日间社会功能的一种状况。
造成失眠的原因有很多:
①心理因素:生活中的重大事件,导致情绪激动、不安,或者持续的精神紧张,都有可能导致失眠。

②生理因素:年龄、性别、饥饿、过饱、女性激素水平变化等也是诱发失眠的因素。

③环境因素:睡眠环境突然改变、强光、噪音等都有可能影响睡眠。

④药物因素:某些药物会导致人体兴奋,干扰睡眠,如甲状腺素、阿托品等。

⑤生活行为因素:睡前看电视玩手机、喝茶、喝咖啡、入睡时间不规律、熬夜工作等都会导致失眠。

⑥个性特征因素:过于细致的个性特征,在失眠中也起一定的作用,如过分关注、过分要求完美、凡事习惯往坏处想。

⑦精神疾病因素:焦虑症、抑郁症、精神分裂症等精神疾病也常会出现失眠。

⑧其他疾病因素:身体的不适也有可能导致失眠,如高血压、慢性胃肠炎、疼痛等。

失眠会使正常的工作生活受到影响,黑眼圈、气色差、老得快都只是小case,失眠还有可能导致记忆力差、免疫力下降、甚至性功能减退。

更严重的是失眠症还可能勾搭上抑郁症、焦虑症等精神疾病,还有糖尿病、高血压、冠心病这类心血管、代谢类疾病。搞不好还会中风、猝死!
核心是建立睡觉和床的关系,让你一看到床就想睡觉。
①只在有睡意的时候才上床,如果20分钟还睡不着,就离开床,等有睡意再上床;
②上床前把手机、遥控器、食物都放得远远的,不做与睡觉无关的事情;
③不管睡得怎样,都在固定时间起床,白天不补觉,坚持到晚上再睡。

进行缓慢的深呼吸训练、练练气功、做做瑜伽、听听柔和舒缓的音乐,想象自己躺在温暖的阳光下,在海边倾听海浪声,都是不错的选择,使心情舒畅、身心放松,争取睡个好觉。

茉莉花、薰衣草、迷迭香之类的植物都有助眠作用,可以在卧室里摆放这些花草,懒人可以选择香薰灯、香薰包、香薰炉、薰衣草枕头来助眠。

许多食物都有安神助眠的作用,如莲子、百合、红枣、桂圆等,可以煲个桂圆莲子汤,但不宜在睡前1小时食用,避免使胃负担过重,反而睡不着。

君康能阳光屋萃取远红外线中5.6~15微米的阳光精华,此段精华被称为“生命的光线”。是人类赖以生存和维持健康必不可少的物质。

阳光精华能渗透人体皮肤4~5cm,直接作用于深层组织,补充细胞能量。

阳光精华与人体细胞产生同频共振效应,让全60万亿个细胞活跃起来。
阳光精华的能量让身体由内而外的温热起来,促进血液循环,加快新陈代谢,调节副交感神经(副交感神经具有安宁镇定的功能),安神助眠,从而预防和改善失眠。

坚持打卡君康能阳光屋
促进血液循环
调节副交感神经,安神助眠

